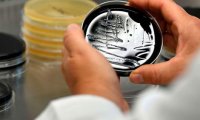
Российские медики разработали карту стойкости к антибиотикам

В Петербург приедет автор «Игры престолов»
Так, в августе этого года в Петербург приедет культовый в последние годы фантаст Мартин. Мировую известность писатель получил, прежде всего, благодаря циклу книг под названием «Песнь льда и пламени».

Так, в августе этого года в Петербург приедет культовый в последние годы фантаст Мартин. Мировую известность писатель получил, прежде всего, благодаря циклу книг под названием «Песнь льда и пламени».

Муж начал избивать ревнивицу кулаками, часть ударов пришлась по голове. Потерпевшей становилось плохо на глазах, однако, испугавшись ответственности за содеянное, мужчина вызывать на помощь врачей не...

22 декабря 2016 года в районе улицы Опытной двое нанятых злоумышленников напали на женщину тридцати девяти лет, избили ее, пытались задушить, а потом, думая, что она мертва, кинули в овраг.

Однако директор территории рассказала, что животное не умерло. Лошадь по кличке Ласка жива и здорова для своего возраста, хотя в последнее время частенько стала падать.

Обвиняемые, занимающие должности в своем управлении, в феврале этого года выяснили, что парень из Новосибирска регулярно покупает синтетические наркотики, заказывая их через мессенджер.

Обвиняемый, будучи в состоянии алкогольного опьянения, поссорился со своей женщиной 23 августа прошлого года. Когда сожительница ушла из принадлежащей ей квартиры, он поджег ее вещи.

Выяснилось, что ребенка пригласила к себе во двор погулять соседская девочка. Когда она открыла калитку, сторожевой пес набросился на маленького гостя.

Преступник похитил четыре трехметровые рельсы с территории одного из предприятий. Чтобы донести и сдать на металлолом, ему потребовалась помощь, которую он стал искать на улице.

Роженица нарушила запрет медиков и на ночь уложила младенца спать рядом с собой. Вероятно, ночью во сне она случайно стукнула его своей рукой по голове, а к утру заметила, что малыш умер.

Мужчина обратился в полицию. Правоохранители быстро вычислили похитителей. Ими оказались двое студентов 19 и 22 лет. У них нашли и похищенные аккумуляторы.

В 8 утра она уже находилась в операционной под наркозом, а медики ждали приезда спасателей, которые должны были освободить конечность из металлического прибора.

Три года назад обвиняемая стала жить с молодым человеком. В трезвом состоянии 24-летний сожитель вел себя нормально, но когда выпивал, то становился агрессивным.

Материалы о преступлении были переданы в областное Следственное управление. В отношении подозреваемого возбуждено уголовное дело по соответствующей статье УК РФ.

Четвертого апреля тридцатидвухлетний подозреваемый находился в гостях в квартире знакомых по ул. Крахмалева со своей тридцатисемилетней сожительницей.
Российские специалисты изобрели интерактивную карту кишечного резистома, которая позволяет узнать географическую распространенность кишечных бактерий у людей.

Туризм всегда был одной из главных отраслей Крыма. После воссоединения полуострова с Россией начали решаться самые главные проблемы, в которых нуждалась отрасль – транспорт, дороги, инфраструктура и...

Крошечные тропические рыбки развили уникальный в своем роде способ защиты с использованием пептидов, которые по своему действию похожи на морфин и героин.

Экологи бью тревогу. Рост промышленности в Китае, который влечет за собой сжигание большого количества угля, приводит к тому, что здоровье жителей страны сильно ухудшается.

Научные сотрудники Лондонской школы экономики и политических наук в результате своих исследований определили самый счастливый возраст в жизни человека.

Проблема хранения и структурирования данных достаточно сложна и решается с помощью создания баз данных. Хранение данных видеонаблюдения представляет особую проблему, и выбор стратегии хранения...